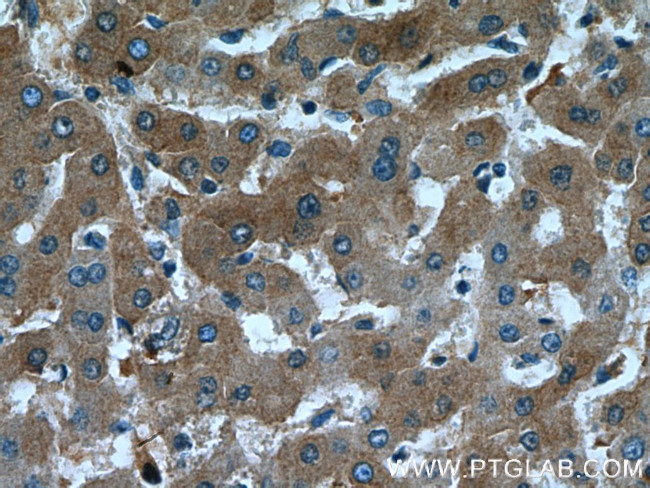
Fetuin-A Antibody in Immunohistochemistry (Paraffin) (IHC (P))

Search
Proteintech
Fetuin-A Polyclonal Antibody
{{$productOrderCtrl.translations['antibody.pdp.commerceCard.promotion.promotions']}}
{{$productOrderCtrl.translations['antibody.pdp.commerceCard.promotion.viewpromo']}}
{{$productOrderCtrl.translations['antibody.pdp.commerceCard.promotion.promocode']}}: {{promo.promoCode}} {{promo.promoTitle}} {{promo.promoDescription}}. {{$productOrderCtrl.translations['antibody.pdp.commerceCard.promotion.learnmore']}}
产品信息
16571-1-AP
种属反应
宿主/亚型
分类
类型
抗原
偶联物
形式
浓度
规格
纯化类型
保存液
内含物
保存条件
运输条件
产品详细信息
Immunogen sequence: MKSLVLLLC LAQLWGCHSA PHGPGLIYRQ PNCDDPETEE AALVAIDYIN QNLPWGYKHT LNQIDEVKVW PQQPSGELFE IEIDTLETTC HVLDPTPVAR CSVRQLKEHA VEGDCDFQLL KLDGKFSVVY AKCDSSPDSA EDVRKVCQDC PLLAPLNDTR VVHAAKAALA AFNAQNNGSN FQLEEISRAQ LVPLPPSTYV EFTVSGTDCV AKEATEAAKC NLLAEKQYGF CKATLSEKLG GAEVAVTCTV FQTQPVTSQP QPEGANEAVP TPVVDPDAPP SPPLGAPGLP PAGSPPDSHV LLAAPPGHQL HRAHYDLRHT FMGVVSLGSP SGEVSHPRKT RTVVQPSVGA AAGPVVPPCP GRIRHFKV (1-367 aa encoded by BC048198)
靶标信息
Alpha2-HS glycoprotein (AHSG), a glycoprotein present in the serum, is synthesized by hepatocytes. The AHSG molecule consists of two polypeptide chains, which are both cleaved from a proprotein encoded from a single mRNA. It is involved in several functions, such as endocytosis, brain development and the formation of bone tissue. The protein is commonly present in the cortical plate of the immature cerebral cortex and bone marrow hemopoietic matrix, and it has therefore been postulated that it participates in the development of the tissues. However, its exact significance is still obscure.
仅用于科研。不用于诊断过程。未经明确授权不得转售。
生物信息学
蛋白别名: Alpha-2-HS-glycoprotein; Alpha-2-Z-globulin; Ba-alpha-2-glycoprotein; Fetuin-A; FetuinA; unnamed protein product
基因别名: A2HS; AHS; AHSG; APMR1; FETUA; HSGA; PRO2743
UniProt ID: (Human) P02765
Entrez Gene ID: (Human) 197